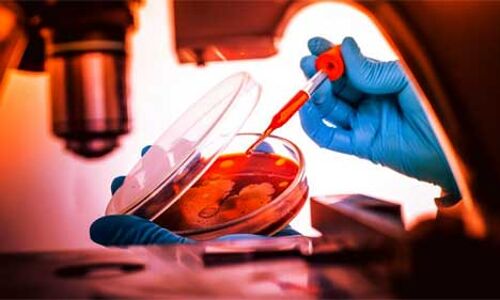
खुलासा : 5 साल से चीन-पाकिस्तान मिलकर बना रहे हैं जैविक हथियार, भारत के खिलाफ होगा उपयोग !

- Home
- /
- China'

China'
Get Latest News, Breaking News about China' - Page 14. Stay connected to all updated on China'
खुलासा : 5 साल से चीन-पाकिस्तान मिलकर बना रहे हैं जैविक हथियार, भारत के खिलाफ होगा उपयोग !
- By 26 Aug 2020 10:14 PM IST
अमेरिका की चीन के खिलाफ बड़ी कार्रवाई, 24 कंपनियों और अधिकारियों को किया ब्लैक लिस्ट
- By 26 Aug 2020 9:20 PM IST
भारत अगले महीने चीन और पाकिस्तान के साथ रूस में एक संयुक्त युद्धाभ्यास करेगा
- By 25 Aug 2020 10:29 AM IST
चीन के साथ अगर बातचीत से नहीं सुलझा मामला तो लद्दाख में सैन्य कार्रवाई पर विचार : जनरल रावत
- By 24 Aug 2020 10:32 AM IST
चीन ने सीमा पर मिसाइल प्लेटफार्म किया तैयार, सैनिको की बढ़ाई संख्या
- By 20 Aug 2020 7:52 PM IST
बाइडेन के चुनाव प्रचार अभियान से लगेगी चीन-पाकिस्तान को मिर्ची, भारत-अमेरिका संबंधों की मजबूती पर होगा जोर
- By 16 Aug 2020 1:16 PM IST
स्वतंत्रता दिवस : राष्ट्रपति कोविंद ने चीन को दिया कड़ा संदेश, अशांति पैदा करने पर मिलेगा जवाब
- By 14 Aug 2020 8:17 PM IST
चीन के ग्लोबल टाइम्स अखबार की हरकत, कश्मीर पर भारत का पक्ष प्रकाशित करने से किया इनकार
- By 14 Aug 2020 7:30 AM IST